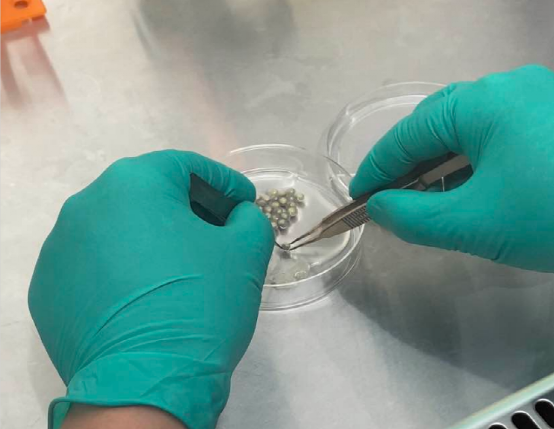

种质资源库建设是保护生物多样性的一项重要战略措施,特别是对珍稀濒危物种而言。“十四五”期间,中华鲟研究所全面提速对珍稀特有鱼类种质资源库建设工作,包括精子库、细胞库、基因库的建设工作等,其中细胞库的建设工作于近期取得新进展。
图为正在进行中华鲟胚胎外膜的剥离
经过前期的科学研究和积累,中华鲟研究所建立并完善了中华鲟、长江鲟细胞库建设的操作技术标准,并在业内首次成功分离保存了中华鲟、长江鲟等濒危鲟鱼的胚胎细胞(胚胎细胞是由受精卵发育形成,经过受精卵n次分裂而产生的细胞)。

图为科研人员正在进行圆口铜鱼种质资源保存工作
近期,着重针对齐口裂腹鱼、圆口铜鱼、白甲鱼等难以驯化和养殖的金沙江流域珍稀特有鱼类进行细胞培养工作,突破了其细胞培养的技术难点,成功保存了这些珍稀鱼类的宝贵资源,并建立了细胞资源的质量控制技术标准,该项技术的成功突破为长江流域珍稀特有鱼类的种质保护增添了技术保障,为未来濒危物种的复活复壮提供了基本的材料保障。

图为A:中华鲟性腺细胞; B:中华鲟胚胎细胞; C:长江鲟鳍条细胞;
D:铜鱼心脏细胞; E:齐口裂腹鱼鳃丝细胞; F:白甲鱼脾脏细胞
下阶段,中华鲟研究所将立足于长江水生物多样性保护和资源恢复需要,全面实施长江全流域重点保护鱼类种质资源收集保存工作,加快解决长江珍稀濒危物种和生物多样性保护面临的突出问题,为更好地实施长江大保护战略贡献力量。